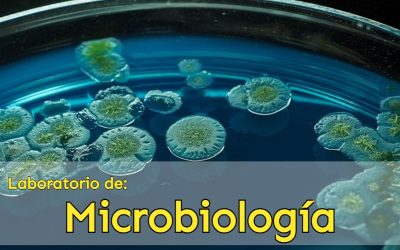
Convocatoria Interna: Personal académico de base interesado a cubrir vacante de Técnico Académico «A»

Universidad Autónoma Agraria Antonio Narro
Desde 1923 formando profesionistas Agrónomos para el desarrollo del campo y la investigación en México.
OFERTA EDUCATIVA
DOCENCIA
INVESTIGACIÓN
POSGRADO
DIRECTORIO DE FUNCIONARIOS
TRANSPARENCIA
SIIAA
BIBLIOTECA
CENTRO DE CÓMPUTO
CURSOS EN LÍNEA
CORREO ELECTRÓNICO
ALUMNOS LICENCIATURA
ALUMNOS POSTGRADO
PROFESORES- SNI
PROFESORES-PRODEP
PROGRAMAS DE LICENCIATURA
ACTIVIDADES
PRÓXIMOS EVENTOS
There are no upcoming events at this time